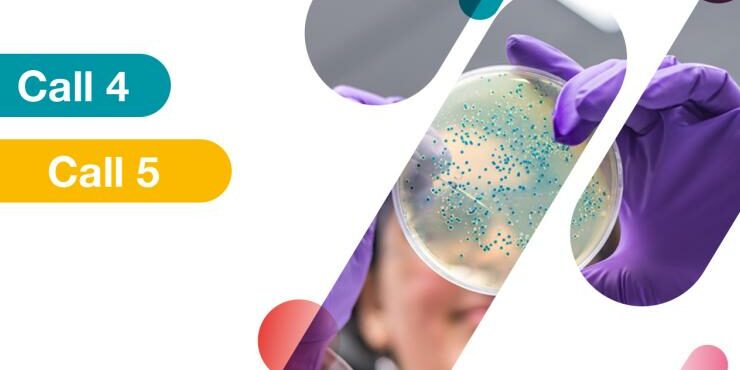

The Innovative Health Initiative (IHI) has revealed the potential topics for inclusion in their upcoming calls for proposals. With the aim of enabling potential applicants to begin preparations, IHI has decided to publish the draft topic texts ahead of the official call launch, scheduled for summer 2023.
IHI call 4 (two-stage call)
- Expanding translational knowledge in minipigs: a path to reduce and replace non-human primates in non-clinical safety assessment
- Patient-centric blood sample collection to enable decentralised clinical trials and improve access to healthcare
- Inclusive clinical studies for equitable access to clinical research in Europe
- Establishing novel approaches to improve clinical trials for rare and ultra-rare diseases
- Safe & sustainable by design (SSbD) packaging and single use device solutions for healthcare products
- Sustainable circular development and manufacturing of healthcare products and their quantitative environmental impact assessment
IHI call 5 (single-stage call)
- Accelerating the implementation of new approach methodologies and other innovative non-animal approaches for the development, testing and production of health technologies
- Development and proof of principle of new clinical applications of theranostics solutions
- Improved prediction, detection, and treatment approaches for comprehensive stroke management
- Maximising the potential of synthetic data generation in healthcare applications
Note that the topics are currently under consultation with the States’ Representatives Group and Science and Innovation Panel. They may therefore change considerably between the versions published here and the call launch, and applicants should check the final, approved topic texts once the calls are launched.
To provide potential applicants with the necessary information and assistance, IHI has organized the IHI Call Days, scheduled to take place online from June 19 to June 29. These informative sessions will cover the details of calls 4 and 5. The IHI Call Days aim to provide potential applicants with the information they need to put together a strong proposal, and give them the opportunity to identify and meet partners for their consortia.